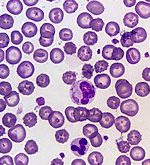

The National Pasta Association has named the month of March as National Noodle Month. Here are some fun facts about our favorite comfort food: It is believed that the first noodles were made about 4,000 years ago in China. Evidence […]
President’s Economic Stimulus
The primary election season is now in full swing. While all of the politicians are out campaigning, President Termite Terry is working behind the scenes, and delivering on his promise to make our economy grow. Here are just a few […]
Curbing The Rising Sales Of Illegal Pesticides
A new multistate task force is out to curb the rising sales of illegal pesticides. The effort is being headed by Mike Weyman, deputy director of Clemson University’s Regulatory Service unit. Mr. Weyman says that the quantity of cases is […]
California Warns Pet Owners
The California Department of Fish and Wildlife (CDFW) is warning pet owners of an unusually high number of canine distemper virus (CDV) cases in wildlife populations statewide. The CDV can infect a wide range of domestic and wild carnivores, including […]
Rave Reviews!
“We recently purchased a home and the property needed to be tented ahead of the move in. We received a few quotes, and were overwhelmed by the process, the price, and also had some concerns about possible damage to new […]
Quote From The Inventor Of The Telephone
“America is a country of inventors, and the greatest inventors are the newspaper men.” Alexander Graham Bell, born March 3, 1847
70 Years Ago . . .
On March 8, 1950, Volkswagen launched the Type 2/Transporter van – also known as the VW Camper, Bus, Microbus, or Kombi. It became the best-selling van in history.
Dryrot – The Cancer Of Wood
Many homeowners in the Orange County area are very familiar with the damage caused by dryrot. It can be seen in structural lumber, eave areas, facia boards, doors, windows, patio covers, wood decks, and in almost anything that is made […]
Pest Control Newsletter February 2020
Fun Facts About The Daytona 500
The 62nd running of the Daytona 500 is scheduled for February 16th and this year’s race will surely be another one for the record books. Here are some fun facts about the “Great American Race”: This track can hold 101,500 […]
President’s Economic Stimulus
Our politicians in Washington D.C. are so busy with the impeachment trial and they appear to be doing almost nothing to improve our nation’s economy. Fortunately, President Termite Terry is still quietly working behind the scene and doing his best […]
Actress Trapped In A Bedbug-Infested Room On Cruise Ship
A lawsuit has been filed on behalf of an actress and her husband, against a major cruise line. The couple was trapped in a stateroom that was infested with bedbugs during a recent cruise from Los Angeles to Mexico. “Imagine […]
Rave Review!
“Terry and Brayden get an A+ from me. Highly recommended. They were punctual, professional, honest, and serious about getting those darn termites! Here’s my short story: On a Saturday, I was about to enter my enclosed kitchen and saw […]
Remembering Steve Jobs
“Design is a funny word. Some people think design means how it looks. But of course, if you dig deeper, it’s really how it works.” Steve Jobs, born February 24, 1955
70 Years Ago . .
On February 8, 1950, the first-ever payment by credit card was made. The founders of Diners Club (now Diners Club International) paid their restaurant bill at Major’s Cabin Grill in New York City.